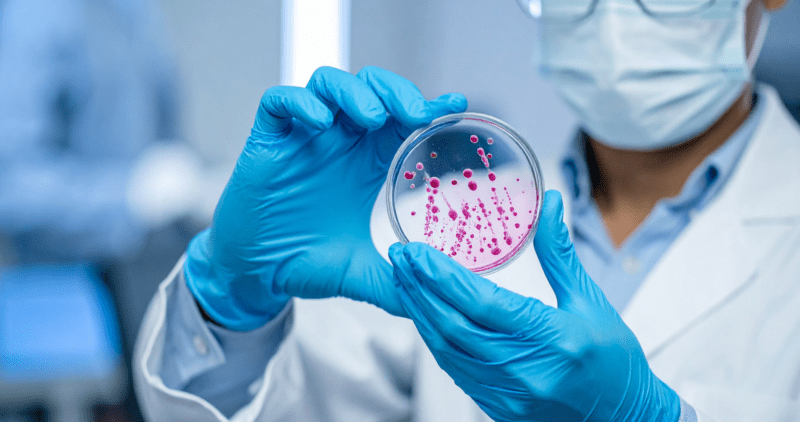

The Alpha-1 Foundation (A1F) is proud to provide a monthly list of articles from researchers that have been funded by […]
The Big Red Alphas Scoop Up Success
The third annual Big Red Alphas Ice Cream for Alpha-1 annual fundraiser brought the community together on Saturday, June 27, at the Natural Resources Center within the Chalco Hills […]